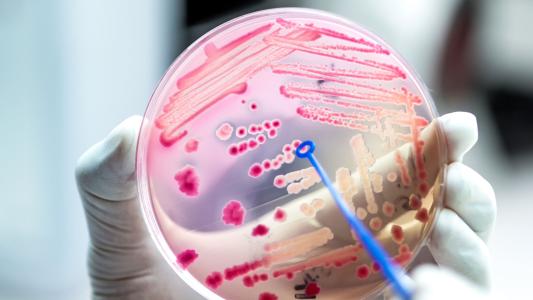
new antibiotic

The future of fertility, from artificial wombs to AI-assisted IVF
A look back at the history of infertility treatments and ahead to the tech that could change everything we thought we knew about reproduction.
The exciting research that may cure Parkinson’s
GeneCode is developing a drug it hopes won’t just alleviate Parkinson’s symptoms but also protect and restore patient’s neural health.
Beyond screen time: Rethinking kids’ tech use with the “Goldilocks hypothesis”
The “Goldilocks hypothesis” asks parents to think beyond screen time and consider the habits that teens build around technology use.